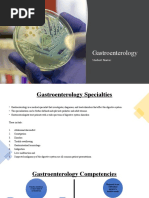

Assignment # 4
Q1: What is a policy, why a policy is formed, comparison of a policy on any topic one
made by Pakistan and one by any other country.
Policy
A policy is a set of guidelines for how to deal with issues and situations. This is widely used
by a lot of companies and organizations that work with different kinds of people. A policy,
such as a company policy, corporate policy, employee policy, etc., is helpful in providing
people with guidance for decision-making.
Policy Formed
Making people's lives better is the main objective of formulating policy. The policies made
by officials further a specific state or public goal. Regardless matter whether the ideas come
from inside or outside of the government, public officials are responsible for creating policy.
Trade Policy of Pakistan
This Trade Policy Framework is based on the following pillars:
1. Rendering exports, a national priority, and the primary driver of economic growth,
that is both inclusive and sustainable, and is the main viable source of foreign
exchange earnings.
2. Enhancement of exports via a collaborative and cohesive national effort engaging all
relevant ministries, departments, government agencies and private sectors to ensure
policy coherence.
3. Introduction of strategic interventions in priority sectors under ‘Make in Pakistan’
initiative. These interventions have been identified in the Action Matrices.
4. Alignment of Trade Policy in tandem with macro-economic framework and other
national policies such as Taxation, Revenue, Textiles & Industrial Policy, etc.
�Foreign Trade Policy of India
Trade enables economic growth and national development. The main aim is not the mere
earning of foreign exchange but encouraging greater economic activity. The foreign trade
policy of India is based on the following major objectives as follows:
1. To enable substantial growth in exports from India and import to India to boost the
economy.
2. To at least double the percentage share of global merchandise trade conducted within
the next five years.
3. To improve the balance of payment and trade.
4. To act as an effective instrument of economic growth by creating employment
opportunities for the citizens; the larger the expansion of trade activities, the more the
workforce required.
5. To provide for sustainable growth by giving access to essential raw materials for
production and other components, consumables, and capital goods required for
increasing production and providing efficient services.
6. To raise the technological capacity for production and cost-effectiveness of industry
and services, thereby improving their competitive strength in comparison to other
countries, and to encourage the accomplishment of internationally accepted standards
of quality.
7. To provide buyers or clients with high-quality goods and services at globally
competitive rates and quality. ‘Canalization’- an important feature of Foreign Trade
Policy under which specific class of goods can be imported only by designated
agencies.
8. Creation of opportunities by engaging in good and ethical practices.
9. Accelerating the economy from low-level economic activities to high-level economic
activities by making it a globally oriented and vibrant economy
10. To derive maximum benefits from expanding the global market and seizing the best
opportunities available.
11. Making policies that favour ease of doing business and e-governance.
12. To allow for hassle-free transactions for both import and export.
13. Reducing the interference between the exporters and Directorate General of Foreign
Trade by reducing the number of export documents.
� 14. To allow the import of technology and equipment’s which may help in achieving
better international standards of quality and reduce the cost of production.
15. Establishing the Advance Licensing System for imported goods needed for
manufacturing various goods for export. An Advance License is issued by the
Directorate General of Foreign Trade to allow duty-free import of inputs, which are
physically integrated with the export product (making normal allowance for wastage).
16. To allow the import of certain goods as listed in the Open General License; a kind of
export license which is issued by the Government to domestic suppliers.
References:
1. Trade Policy Framework (STPF) 2020-25. (n.d.). Retrieved October 13, 2022, from
https://tdap.gov.pk/wp-content/uploads/2022/01/STPF-2020-25.pdf
2. arora, S. (2019, September 3). What are the objectives of Foreign Trade Policy in
India? Legodesk. https://legodesk.com/legopedia/foreign-trade-policy-india/